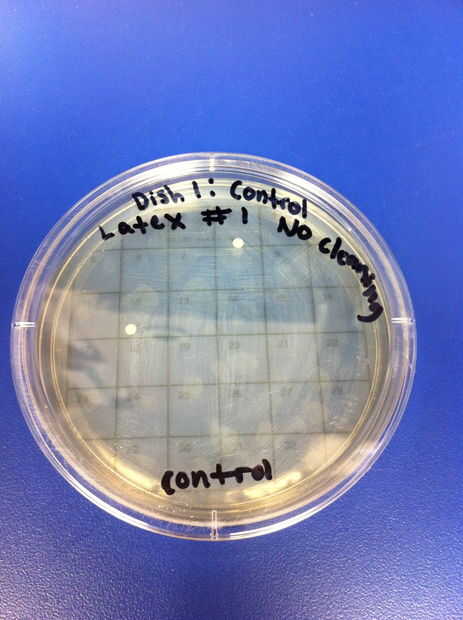
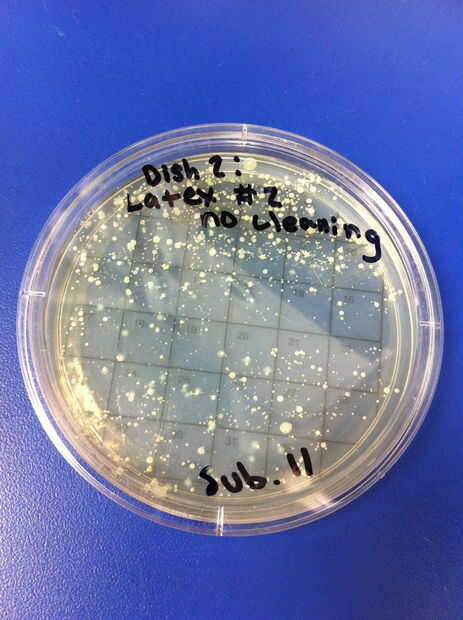
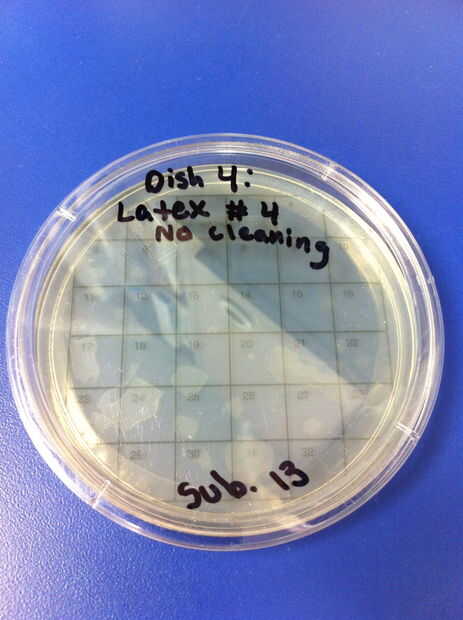
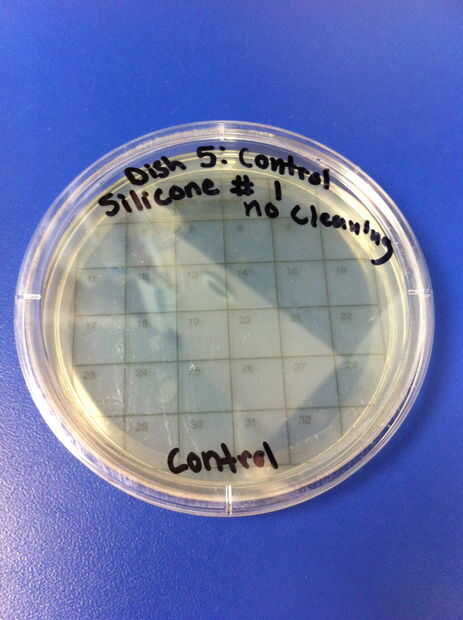
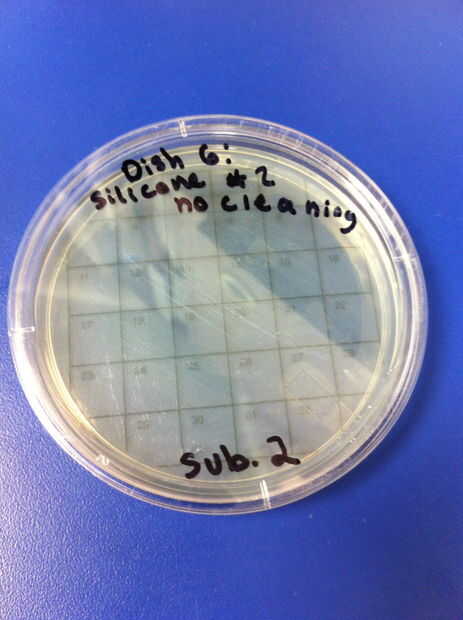
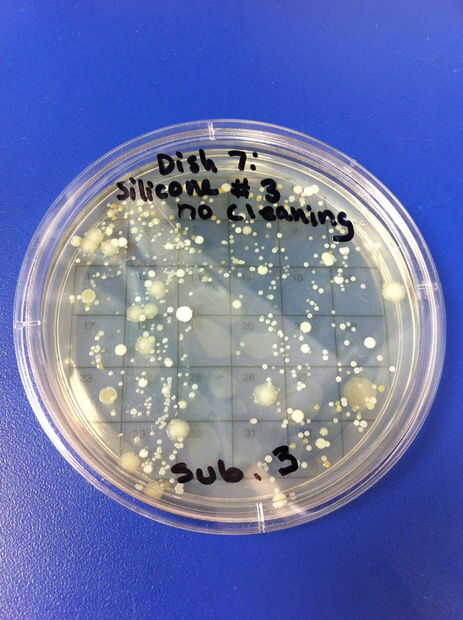
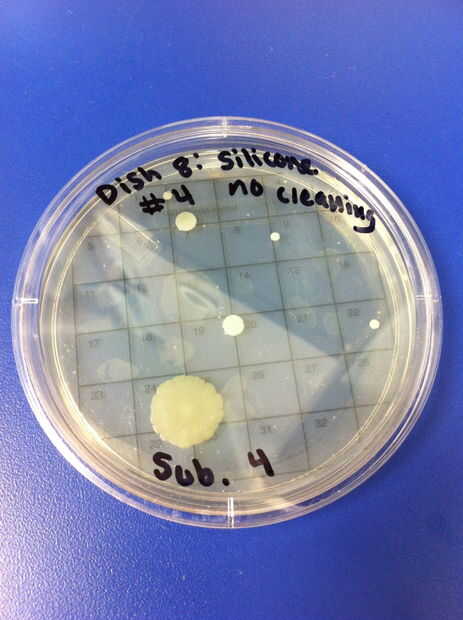
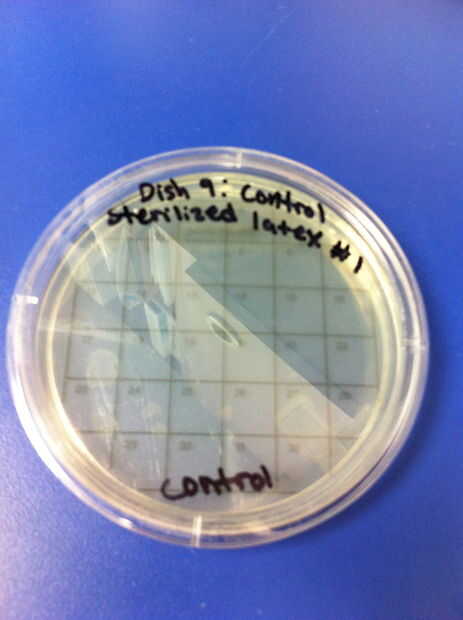
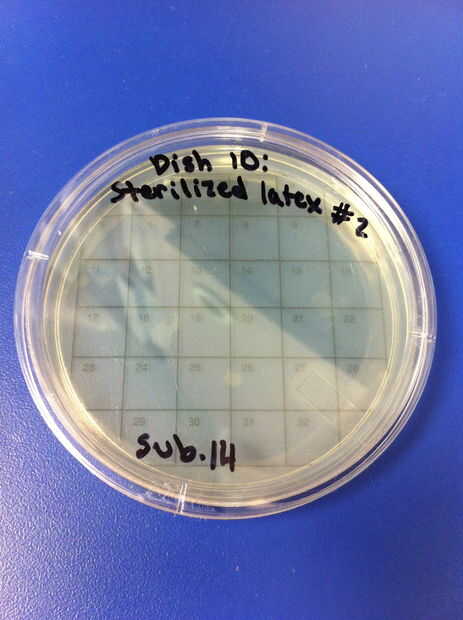
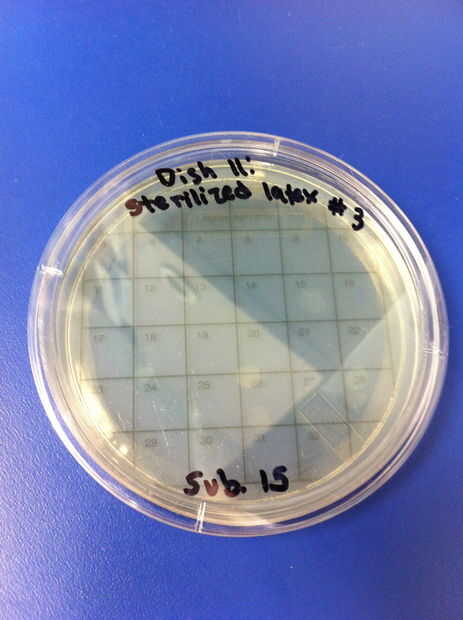
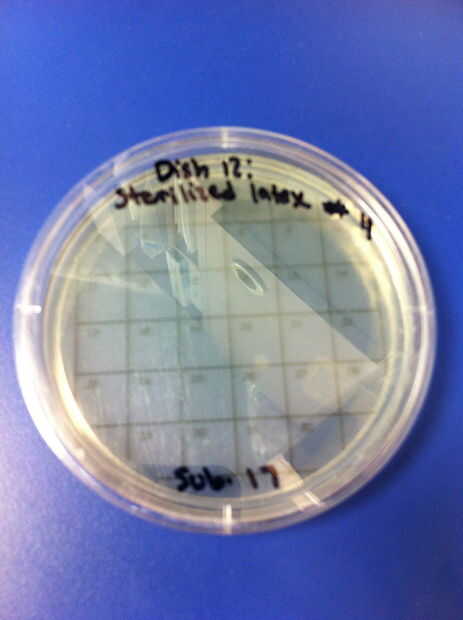
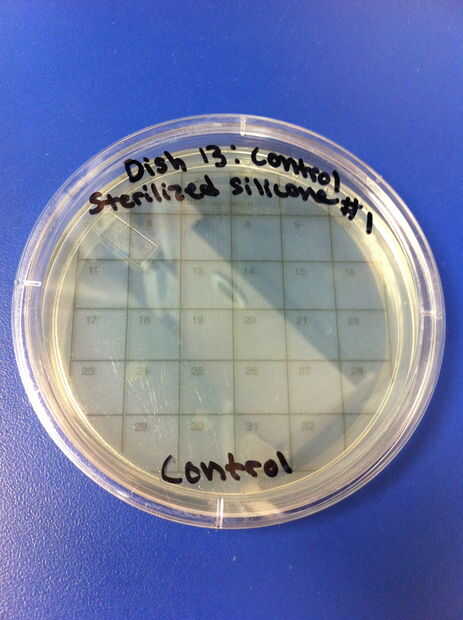
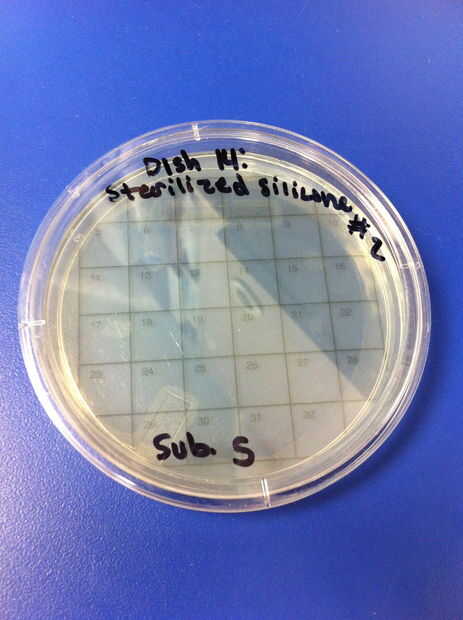
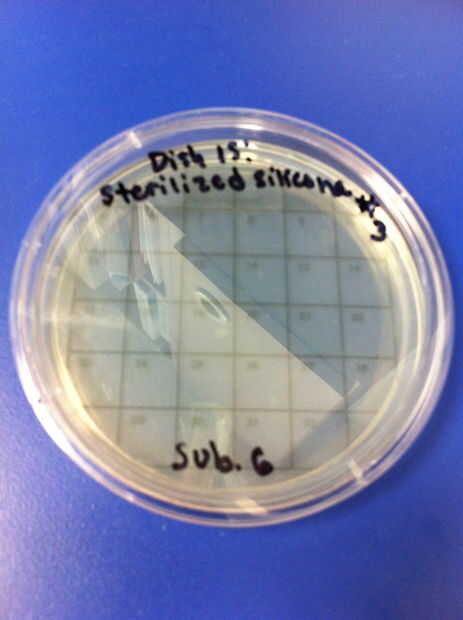
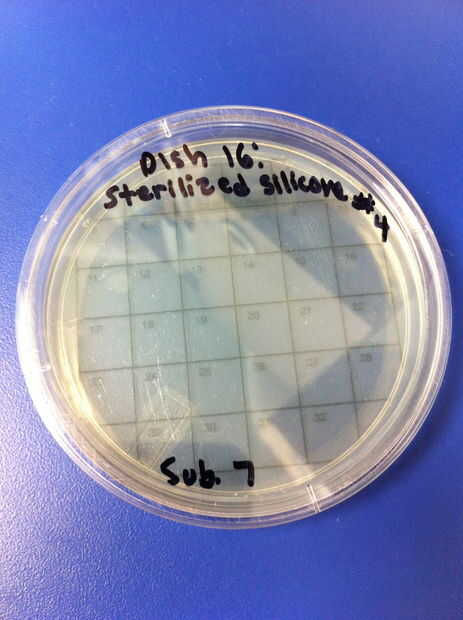
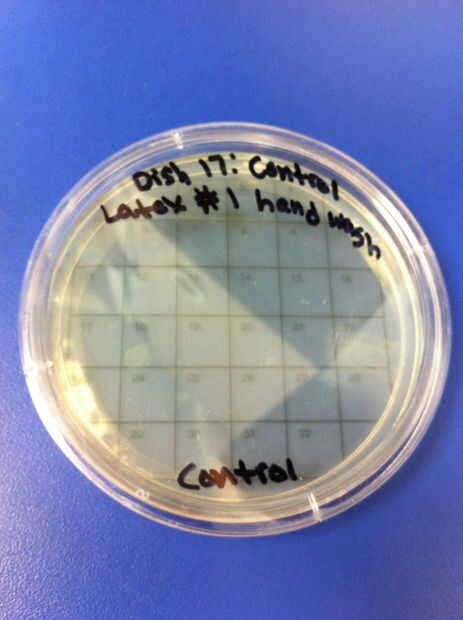
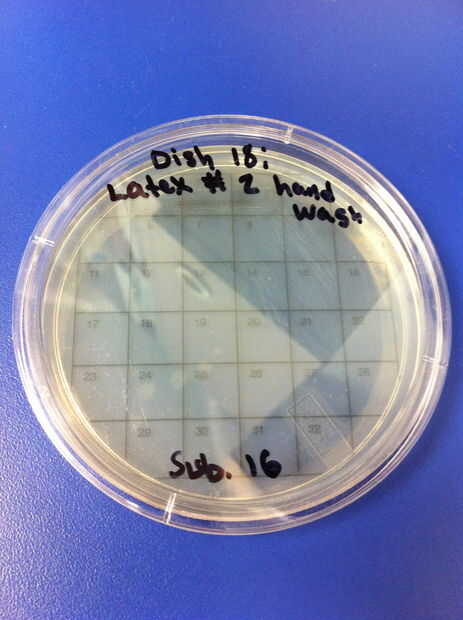
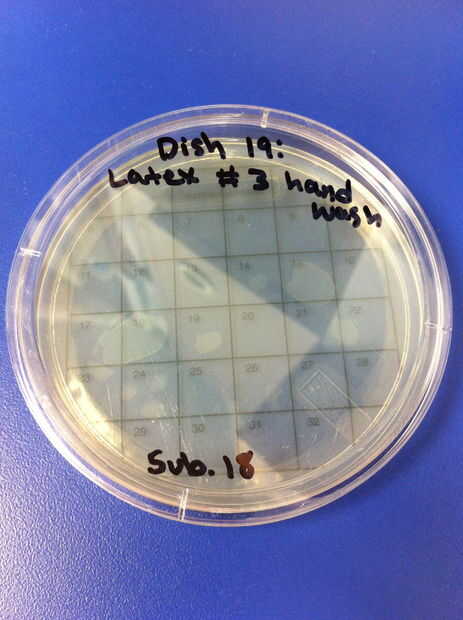
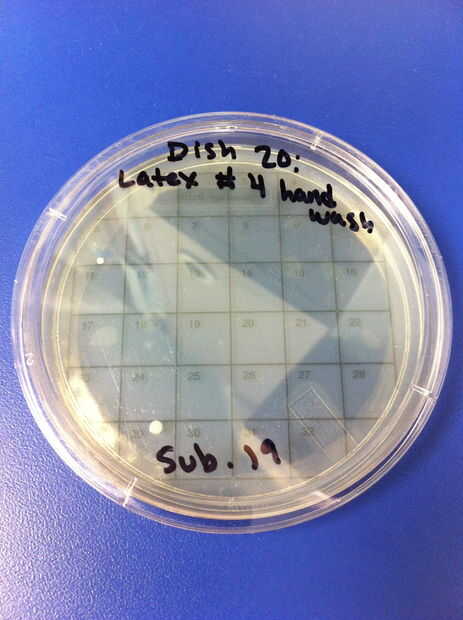
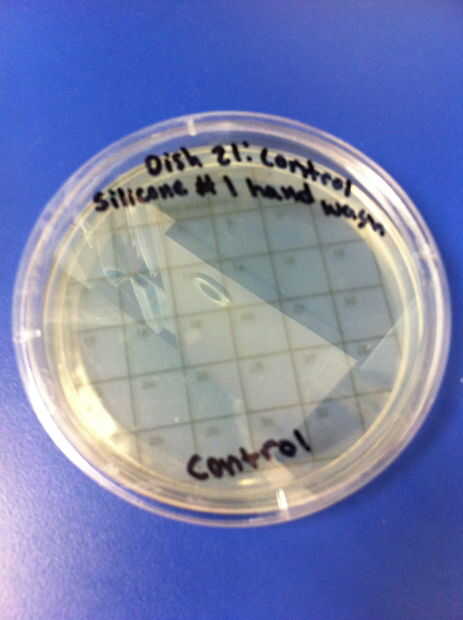
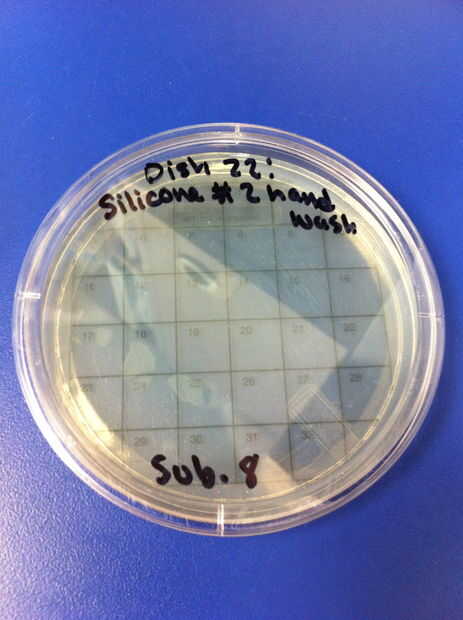
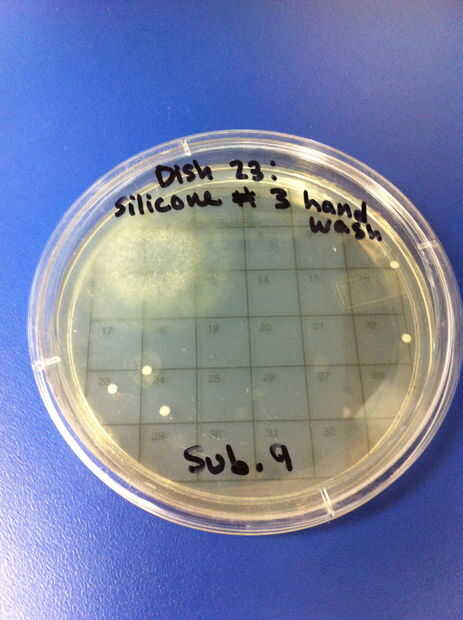
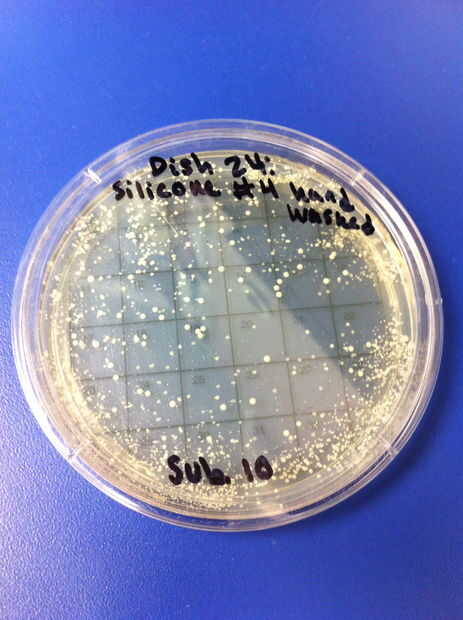

Paso 6: resultados

1-4 los ensayos se realizaron utilizando látex chupetes y ningún método de limpieza. El porcentaje de redes de Petri por colonias (de 32) en el chupete de control fue de 6,25%. El porcentaje medio de las redes de Petri llenada por las colonias (de 32) en el chupete en el grupo experimental fue de 56,25%. 5-8 los ensayos se realizaron utilizando chupetes de silicona y ningún método de limpieza. El porcentaje de redes de Petri por colonias (de 32) en el chupete de control fue de 0%. El porcentaje medio de las redes de Petri llenada por las colonias (de 32) en el chupete en el grupo experimental fue de 51.04%.
9-12 los ensayos se realizaron utilizando chupetes de látex y el método de limpieza de hervir o esterilizar. El porcentaje de redes de Petri por colonias (de 32) en el chupete de control fue de 0%. El porcentaje medio de las redes de Petri llenada por las colonias (de 32) en el chupete en el grupo experimental también fue 0%. 13-16 los ensayos se realizaron utilizando chupetes de silicona y el método de limpieza de hervir o esterilizar. El porcentaje de redes de Petri por colonias (de 32) en el chupete de control fue de 0%. El porcentaje medio de las redes de Petri llenada por las colonias (de 32) en el chupete en el grupo experimental fue de 0%.
17-20 los ensayos se realizaron utilizando chupetes de látex y el método de limpieza de lavado de manos con jabón y agua tibia. El porcentaje de redes de Petri por colonias (de 32) en el chupete de control fue de 0%. El porcentaje medio de las redes de Petri llenada por las colonias (de 32) en el chupete en el grupo experimental fue de 2.08%. 21-24 los ensayos se realizaron utilizando chupetes de silicona y el método de limpieza de lavado de manos con jabón y agua tibia. El porcentaje de redes de Petri por colonias (de 32) en el chupete de control fue de 0%. El porcentaje medio de las redes de Petri llenada por las colonias (de 32) en el chupete en el grupo experimental fue 41.67%. En general, el porcentaje promedio de redes de Petri por colonias (de 32) en los chupetes de látex fue 19.44% y el porcentaje promedio total de redes de Petri por colonias (de 32) en los chupetes de silicona fue 30.89%.